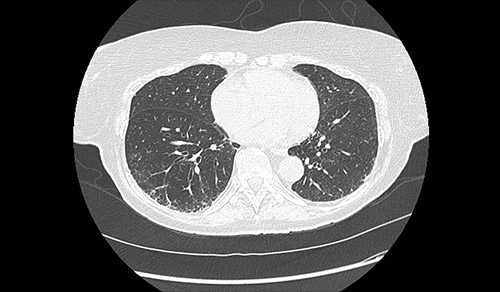

Clinicians from Columbia and Weill Cornell Medicine are at the forefront of pulmonary medicine and lung surgery combine leading-edge therapies with compassionate care for patients with all types and stages of lung disease. Our researchers are contributing to promising advances in acute lung injury, COPD, interstitial lung disease, and pulmonary hypertension.
Pulmonology & Lung Surgery
Featured Updates
The JAMA study examined trends in mitral valve repair and replacement and explained the benefits of undergoing repair at a high-volume center.
The Latest